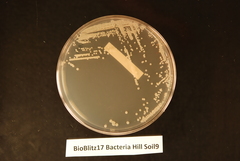
Streptomyces endophyticus

Streptomyces endophyticus: taxon details and analytics
- Domain
- Kingdom
- Bacteria
- Phylum
- Actinobacteria
- Class
- Order
- Actinomycetales
- Family
- Streptomycetaceae
- Genus
- Streptomyces
- Species
- Streptomyces endophyticus
- Scientific Name
- Streptomyces endophyticus
Parent Taxon
Sibling Taxa
- Streptomyces acidiscabies
- Streptomyces alfalfae
- Streptomyces atroolivaceus
- Streptomyces chumphonensis
- Streptomyces diastaticus
- Streptomyces endophyticus
- Streptomyces endosymbiont of venustus
- Streptomyces flavotricini
- Streptomyces flavoviridis
- Streptomyces griseus
- Streptomyces hirsutus
- Streptomyces intermedius
- Streptomyces lanatus
- Streptomyces microflavus
- Streptomyces psammoticus
- Streptomyces rochei
- Streptomyces roseogriseus
- Streptomyces scabies
- Streptomyces similanensis
- Streptomyces violaceus